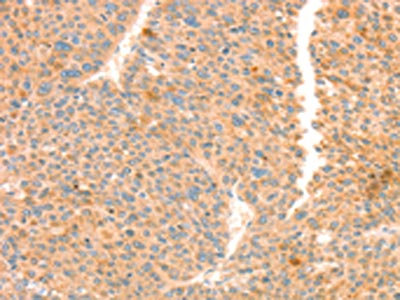

TRPM7 Antibody
-
中文名稱:TRPM7兔多克隆抗體
-
貨號:CSB-PA834491
-
規格:¥1100
-
圖片:
-
The image on the left is immunohistochemistry of paraffin-embedded Human gastic cancer tissue using CSB-PA834491(TRPM7 Antibody) at dilution 1/30, on the right is treated with synthetic peptide. (Original magnification: ×200)
-
The image on the left is immunohistochemistry of paraffin-embedded Human liver cancer tissue using CSB-PA834491(TRPM7 Antibody) at dilution 1/30, on the right is treated with synthetic peptide. (Original magnification: ×200)
-
-
其他:
產品詳情
-
Uniprot No.:
-
基因名:
-
別名:ALSPDC antibody; CHAK antibody; CHAK1 antibody; Channel kinase 1 antibody; Channel-kinase 1 antibody; Long transient receptor potential channel 7 antibody; LTrpC-7 antibody; LTrpC7 antibody; Transient receptor potential cation channel subfamily M member 7 antibody; TRP PLIK antibody; TRPM7 antibody; TRPM7_HUMAN antibody
-
宿主:Rabbit
-
反應種屬:Human,Mouse,Rat
-
免疫原:Synthetic peptide of Human TRPM7
-
免疫原種屬:Homo sapiens (Human)
-
標記方式:Non-conjugated
-
抗體亞型:IgG
-
純化方式:Antigen affinity purification
-
濃度:It differs from different batches. Please contact us to confirm it.
-
保存緩沖液:-20°C, pH7.4 PBS, 0.05% NaN3, 40% Glycerol
-
產品提供形式:Liquid
-
應用范圍:ELISA,IHC
-
推薦稀釋比:
Application Recommended Dilution ELISA 1:2000-1:5000 IHC 1:50-1:200 -
Protocols:
-
儲存條件:Upon receipt, store at -20°C or -80°C. Avoid repeated freeze.
-
貨期:Basically, we can dispatch the products out in 1-3 working days after receiving your orders. Delivery time maybe differs from different purchasing way or location, please kindly consult your local distributors for specific delivery time.
-
用途:For Research Use Only. Not for use in diagnostic or therapeutic procedures.
相關產品
靶點詳情
-
功能:Essential ion channel and serine/threonine-protein kinase. Divalent cation channel permeable to calcium and magnesium. Has a central role in magnesium ion homeostasis and in the regulation of anoxic neuronal cell death. Involved in TNF-induced necroptosis downstream of MLKL by mediating calcium influx. The kinase activity is essential for the channel function. May be involved in a fundamental process that adjusts plasma membrane divalent cation fluxes according to the metabolic state of the cell. Phosphorylates annexin A1 (ANXA1).
-
基因功能參考文獻:
- Data show that melastatin-related transient receptor potential member 7 (TRPM7)-K1648R mutant leads to disruption of protease or purinergic receptor-induced calcium release. PMID: 29500477
- Phosphorylation of S1565 within the exchange domain functions as a regulatory switch to control TRPM7 catalytic activity. PMID: 28220887
- These findings confirm that TRPM6 cannot be replaced by TRPM7, and that TRPM6/7 complexes and TRPM6/7-mediated Mg(2+) influx are indispensable in human epithelial colon cells. PMID: 29912157
- results identify SOX4 as a transcription factor that is uniquely sensitive to cellular tension and indicate that TRPM7 may contribute to breast cancer progression by tensional regulation of SOX4. PMID: 29684587
- Mg ions up-regulated the expression of Runx2 and alkaline phosphatase (ALP) through TRPM7/PI3K signalling pathway, which could significantly enhance the osteogenic activity of human osteoblasts. PMID: 28882757
- forms functional intracellular channels that mediate Zn2+ release from the lumen of a previously unrecognized population of vesicles during oxidative stress PMID: 28696294
- Malfunctions of TRPM7 are associated with anoxic neuronal death, cardiac fibrosis, tumor progression and macrothrombocytopenia. (Review) PMID: 28356194
- Authors observed that the expression of TRPM7 was significantly elevated in bladder cancer tissues compared with that noted in the adjacent non-tumor tissues. Furthermore, increased TRPM7 expression was significantly associated with recurrence, metastasis and prognosis. PMID: 28791418
- TRPM7 role in epithelial-mesenchymal transition, cell migration and invasion in prostate cancer cells PMID: 28573641
- our results in vitro and in vivo have revealed that the downregulation of TRPM7 could reduce the BCa cell proliferation, trigger cell cycle arrest and apoptosis. In conclusion, downregulated TRPM7 could reduce the activity of bladder cancer cells and induce cell apoptosis via ERK1/2 pathway. PMID: 27662662
- We have shown the contributions of TRPM7 in many physiological and pathophysiological processes, including hypoxia and ischaemia [review]. PMID: 27891609
- TRPM7 appears to play an important role in mechanosensing in mesenchymal stem cells. (Review) PMID: 27651019
- Our results show that the activating TRPM7 channel may prevent AD-related Abeta neuropathology via modulating Ca(2+)-regulated basal autophagy. PMID: 28870815
- The results suggest that TRPM7 is required for proliferation, migration and invasion of ovarian cancer cells through regulating multiple signaling transduction pathways and the formation of focal adhesions. PMID: 25450691
- The melastatin-like transient receptor potential cation channel, subfamily M, member 7 (TRPM7), which is responsible for Mg(2+) entry, was studies and [Mg(2+)]i measured in cells stably expressing wildtype CFTR, and two mutant proteins (DeltaF508-CFTR and G551D-CFTR). This study shows for the first time that [Mg(2+)]i is decreased in cells expressing DeltaF508-CFTR and G551D-CFTR mutated proteins. PMID: 26874684
- Variability of the TRPM7 current density in human cardiomyocytes is related to the clinical history, being higher in atrial fibrillation and in ischemic cardiomyopathy. PMID: 28129376
- our results show that TRPM7 is involved in PDAC cell invasion through regulation of Hsp90alpha/uPA/MMP-2 proteolytic axis, confirming that this channel could be a promising biomarker and possibly a target for PDAC metastasis therapy. PMID: 28284058
- Data show that activated TRPM7 activity contributes to the devastating migratory and invasive characteristics of glioblastoma (GBM) . PMID: 28061441
- Bradykinin promoted migration and invasion of hepatocellular carcinoma cells through TRPM7 and MMP2. PMID: 27693494
- chronic aldosterone treatment increases the plasma membrane expression of TRPM7, which is associated with an increase of TRPM7 current. This process occurs via an MR-dependent, genomic signaling cascade involving SGK1 and a functioning TRPM7 alpha-kinase domain. PMID: 27466368
- expression of TRPM7 has an impact on the prognosis of patients with esophageal squamous cell carcinoma PMID: 28314277
- TRPM7 is part of a large cytoskeletal complex that may affect the malignant potential of tumor cells by regulating actomyosin dynamics and cell-matrix interactions. PMID: 27402209
- TRPM7 and STAT3 activation might be critical for the growth of NPC cells. PMID: 26779625
- Data show that resistant cells express lower amounts of the transient receptor potential cation channel subfamily M TRPM6 and 7, both involved in magnesium transport. PMID: 26563869
- TRPM7 dysfunction may cause macrothrombocytopenia in humans and mice. PMID: 27020697
- These results suggest that TRPM7 channel may play a critical role for zinc toxicity associated with stress. PMID: 26780729
- The Different Roles of The Channel-Kinases TRPM6 and TRPM7 PMID: 26179995
- TRPM7 inhibition by siRNA caused an increase in adhesion relative to control, but a decrease to 80% of calcium response relative to non-targeting siRNA which confirms the important role of TRPM7 in mechanotransduction despite the increase in adhesion. PMID: 25946314
- TRPM7 was involved in the regulation of hDPSC proliferation, migration and osteogenic differentiation and may play a role in the dental pulp repair process PMID: 24138320
- Overexpression of TRPM7 expression is significantly associated with poor prognosis in patients with ovarian cancer. PMID: 24935580
- TRPM7 expression closely associates with the migratory and metastatic properties of neuroblastoma cells in vitro and in vivo. TRPM7 controls a developmental transcriptional program involving the transcription factor SNAI2. PMID: 25797249
- Study demonstrates that human glioma cells express functional TRPM7 channel and that activation of this channel plays an important role in the proliferation, migration, and invasion of malignant glioma cells PMID: 25438992
- These results identified a central role of TRPM7 in MSC mechanical stimulation-induced osteogenesis PMID: 25263397
- When TRPM7 channel expression was induced from HEK293 cells in a nutrient-rich condition, LC3-II level increased indicating the increased level of basal autophagy. PMID: 25983327
- N-Myc can promote neuroblastoma cell proliferation through up-regulation of the channel kinases TRPM6 and TRPM7 PMID: 25277194
- Data show that lipopolysaccharide induced vascular endothelial cell migration is mediated by toll-like receptor TLR-4/NF-kappa B pathway and enzyme NAD(P)H oxidase in association with the transient receptor potential melastatin 7 (TRPM7) ion channel. PMID: 25130439
- The TRPM7 single-nucleotide polymorphisms (rs8042919 and rs7173321) are associated with breast cancer in Han Population of Northeast China. PMID: 24952306
- TRPM7 activates JAK2/STAT3 and/or Notch signaling pathways and leads to increased cell proliferation and migration. PMID: 25192910
- Data suggest that the TRPM7 channel negatively regulates the function of vascular endothelial cells. PMID: 25472964
- TRPM7 has been associated with cell proliferation, survival and development and thus correlated with growth and progression of several types of tumor cells PMID: 25069584
- High TRPM7 expression is associated with nasopharyngeal carcinoma. PMID: 25304381
- Data indicate heteromer formation between channel kinases TRPM6 and TRPM7 influences the biological activity of the ion channels. PMID: 24858416
- TRPM7 is a key protein involved in the mechanism underlying endotoxin-induced endothelial fibrosis PMID: 24710004
- Characterized the spatiotemporal evolution of intracellular calcium 'flickers', a signature of cell activation, in response to steady, pulsatile, and oscillatory shear stress, related to the opening of a stretch activated ion channel, TRPM7. PMID: 24445362
- TRPM7 could be essential for initiation and/or progression of prostate cancer. PMID: 24769209
- TRPM7 channels play an important role in hyperglycemia-induced injury of vascular endothelial cells PMID: 24223965
- Study shows that in normal tissues and cell lines, the kinase is proteolytically cleaved from the channel domain in a cell-type-specific manner. These TRPM7 cleaved kinase fragments (M7CKs) translocate to the nucleus and bind multiple components of chromatin-remodeling complexes, including Polycomb group proteins. PMID: 24855944
- Human lung fibroblasts express functional TRPM7 channels that may play a vital role in modulating cell proliferation and differentiation, probably involved in the PI3K/Akt pathway. PMID: 23934071
- TRPM6 modulates the functionality of TRPM7, and the TRPM6 kinase plays a critical role in tuning the phenotype of the TRPM7.M6 channel complex. PMID: 24385424
- TRPM7 alpha-kinase modulates inflammatory signaling by aldosterone in a TRPM7 channel/ Mg2+-independent manner. PMID: 23838006
顯示更多
收起更多
-
相關疾病:Amyotrophic lateral sclerosis-parkinsonism/dementia complex 1 (ALS-PDC1)
-
亞細胞定位:Membrane; Multi-pass membrane protein.
-
蛋白家族:Protein kinase superfamily, Alpha-type protein kinase family, ALPK subfamily; Transient receptor (TC 1.A.4) family, LTrpC subfamily, TRPM7 sub-subfamily
-
數據庫鏈接:
Most popular with customers
-
-
YWHAB Recombinant Monoclonal Antibody
Applications: ELISA, WB, IHC, IF, FC
Species Reactivity: Human, Mouse, Rat
-
Phospho-YAP1 (S127) Recombinant Monoclonal Antibody
Applications: ELISA, WB, IHC
Species Reactivity: Human
-
-
-
-
-